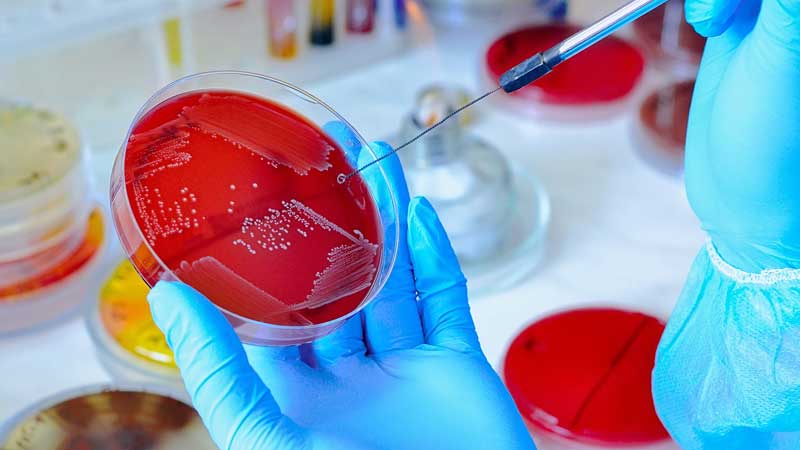

The hematology section within the realm of the pathology laboratory serves as an essential pillar in the diagnosis and management of a wide array of medical conditions. This branch of laboratory medicine is dedicated to the study of blood, blood-forming tissues, and related disorders. By conducting a diverse range of tests and analyses, the hematology department plays a pivotal role in assisting clinicians and healthcare professionals in delivering optimal patient care.

The Routine Clinical Chemistry for blood and other body fluids to detect the health status of patients. We conduct tests Enzymes, Substrates, Electrolytes, Proteins, Therapeutic Drug Monitoring and Drugs of Abuse etc. Latest international technology coupled with digital bidirectional interface promises accurate, reliable and timely results.
Microbiology is about looking for potential pathogenic microbes in humans. This includes bacteria, parasites and fungi. Our Clinical Microbiology Laboratory provides a wide range of services including sexual health screening, enteric pathogens, to multiple resistant organisms. We are also the national reference centre for Mycology, Anaerobes, and molecular typing of Mycobacteria.

The Immunology and Serology Sections within a Pathology Laboratory are integral components dedicated to the study of the immune system and the detection of specific antibodies and antigens in patient samples.

We offer a wide array of tests at the forefront of molecular diagnostics and precision medicine. The real time PCR is the most frequently used molecular technique in a molecular pathology laboratory. We perform molecular testing for microorganisms such as virus (HCV,HBV, Dengue, COVID19 etc) and Bacteria (M. Tuberculosis etc).

The Histopathology Section in a Pathology Laboratory is a specialized area dedicated to the examination of tissues at the cellular and microscopic levels to diagnose diseases. It is a critical branch of pathology that plays a pivotal role in both clinical diagnostics and medical research. Histopathology section is instrumental in diagnosing a wide range of diseases, including cancer, inflammatory conditions, infections, and genetic disorders.
